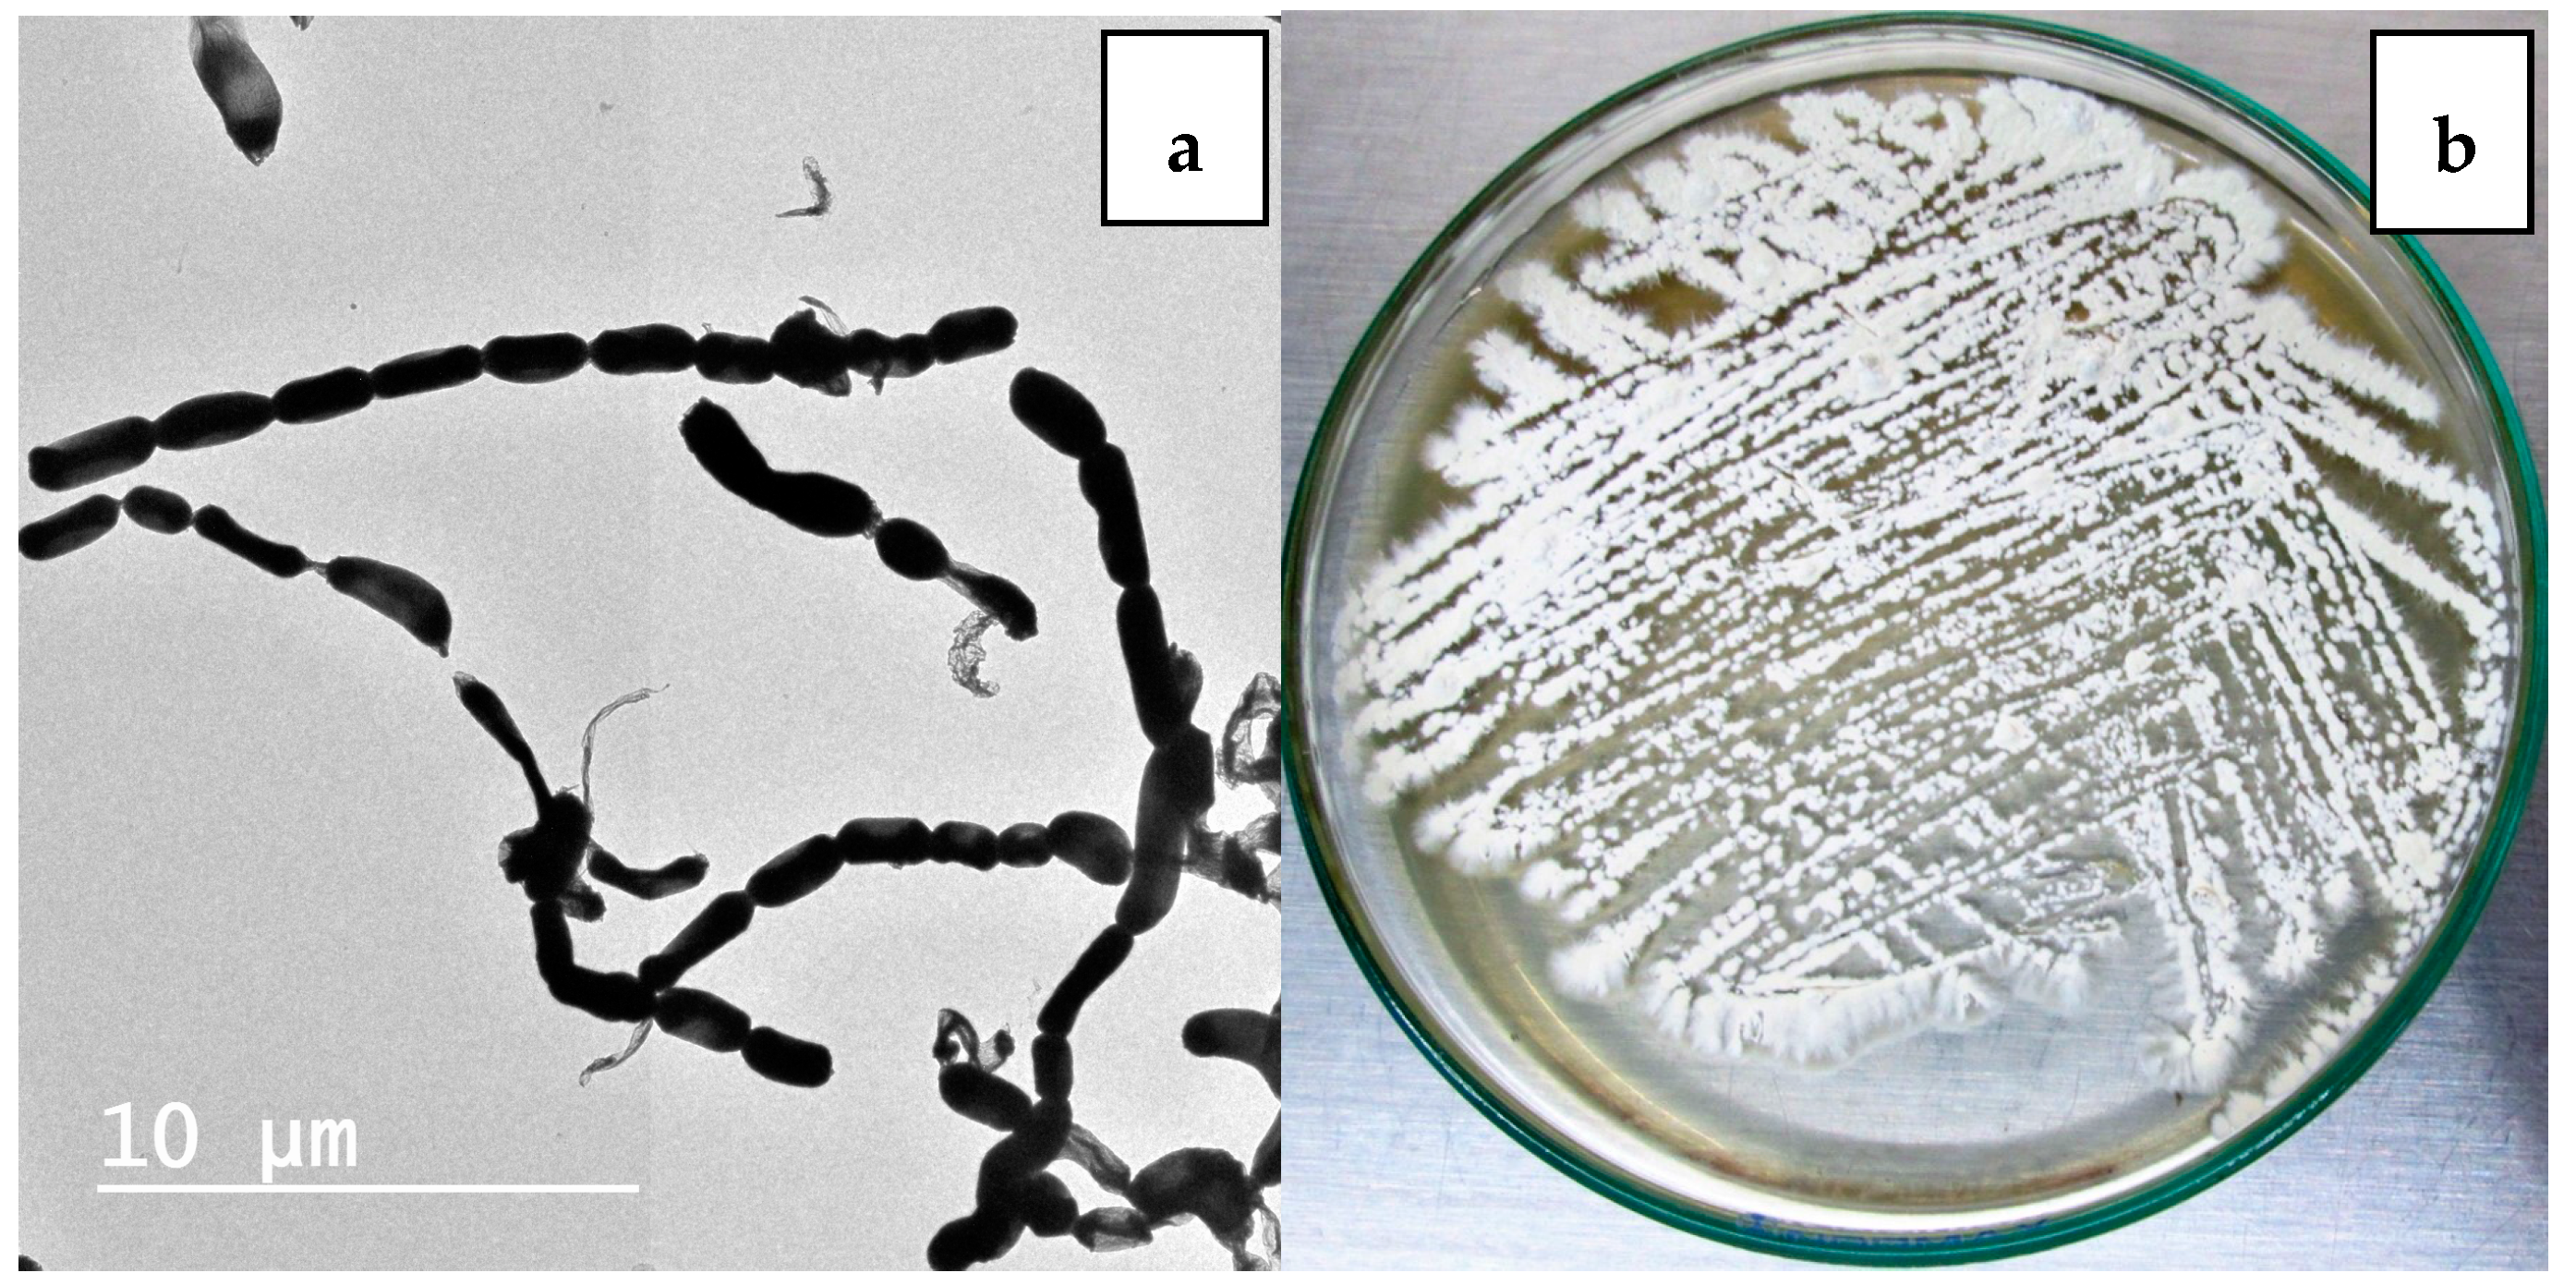
Molecules 23 00299 g002

Abstract
Terretonin N (1), a new highly oxygenated and unique tetracyclic 6-hydroxymeroterpenoid, was isolated together with seven known compounds from the ethyl acetate extract of a solid-state fermented culture of Nocardiopsis sp. Their structures were elucidated by spectroscopic analysis. The structure and absolute configuration of 1 were unambiguously determined by X-ray crystallography. The isolation and taxonomic characterization of Nocardiopsis sp. is reported. The antimicrobial activity and cytotoxicity of the strain extract and compound 1 were studied using different microorganisms and a cervix carcinoma cell line, respectively.
1. Introduction
The adaptation of marine bacteria to harsh environments has led to a rich biological and genetic diversity, so that structural diversity and complex molecular architectures became one of their key features of natural products with a remarkably broad range of biological activities [1,2,3,4,5,6,7]. Accordingly, they represent a potential source of new bioactive compounds for industrial, agricultural, environmental, pharmaceutical, and medical applications [8]. However, there are still many potential sources of new bioactive natural products from bacteria, as many habitats are yet unexplored [9].
Terpenes are an interesting class of bioactive compounds, which are produced biogenetically through either mevalonate or non-mevalonate pathways, comprising diverse skeletal structures (hemi-, mono-, sesqui-, di-, sester-, tri-, sesquart-, and tetraterpenes), and represent the largest group of natural products. They are native to plants (including macroalgae), invertebrates (sponges, soft corals), and fungi [10]. Recently, several terpenoidal and steroidal compounds with unique structures and activities were explored from actinobacteria, highlighting theses microorganisms as attractive sources of diverse bioactive compounds [11,12,13]. One such class of terpenes is known as sesterterpenoids and/or meroterpenoids, a relatively small group of terpenoids found in terrestrial plants, insects, fungi, lichens, and marine organisms [10,14,15,16,17]. They exhibit various bioactivities including antibacterial, antifungal, insecticidal, anti-inflammatory, cytotoxic, antifeedant, and antiaggregatory effects [18,19,20,21,22,23].
In the course of our studies, one new highly oxygenated tetracyclic 6-hydroxymeroterpenoid, terretonin N (1) (Figure 1), was isolated from the ethyl acetate extract of a culture of Nocardiopsis sp. LGO5 fermented on solid medium. At the same time, the known compounds anthranilic acid, 3-indolylacetic acid, Nβ-acetyltryptamine [24], (3R,4R)-3,4-dihydroxy-3-methyl-pentan-2-one, (3S,4R)-3,4-dihydroxy-3-methyl-pentan-2-one [7], sitosteryl-3β-d-glucoside [25], and terrein [26,27] were obtained. The structure of 1 was elucidated using different analytical methods, and its absolute stereochemistry was unambiguosly determined by X-ray crystallography. Details of the isolation, taxonomical characterisation, and bioactivity of compound 1 are presented as well.
Figure 1.
Structure of terretonin N (1).
2. Results and Discussion
2.1. Isolation and Maintenance of the Producing Strain
The strain Nocardiopsis sp. LGO5 was isolated from a sediment sample collected from a lake in Helwan, Egypt. The strain was cultivated on starch-nitrate medium containing 50% natural sea water and incubated at 30 °C. The pure culture was maintained in glycerol at −80 °C and deposited at the Microbial Chemistry Department, National Research Centre, Cairo, Egypt.
2.2. Phenotypic and Genotypic Characteristics
Nocardiopsis sp. LGO5 forms a well-developed white aerial mycelium that turns into grey after 21 days, producing pale brown soluble pigments on starch nitrate agar and inorganic salt agar, whereas no melanoid pigments are formed on either ISP media 6 or 7. The strain shows white aerial mycelium on yeast extract-malt extract agar (Figure 2b). Cellobiose, galactose, glucose, maltose, and xylose, resp., were used as sole carbon sources. The strain grows in the presence of 10% (w/v) NaCl at 30 °C, 37 °C and 40 °C. Microscopically, the spores of LGO5 appear as long chains elongated to open spirals or zig-zags with a smooth surface (Figure 2a and Figure 3).
Figure 2.
(a) Transmission electron micrography of strain showing elongated spores with smooth surface (bar = 10 µm); (b) 10-days age of LGO5 culture on yeast extract malt extract agar.
Figure 3.
Spore chain morphology of strain LGO5 grown on starch-nitrate agar. Light microscopy of sporulating mycelium (1200×) showing long spiral to zig-zag spore chains: (a) in absence of nystatin; (b) in presence of nystatin.
Genetically, 1270 bp of the 16S rRNA gene sequence was amplified from a pure culture of the strain LGO5 using PCR, sequenced, and analyzed using a BLAST-based approach. Phylogenetic analysis of this 16S rRNA gene sequence confirmed a very close relationship of the isolate LGO5 to Nocardiopsis spp. (Figure 4). The evolutionary history was inferred using the neighbour-joining method (Saitou and Nei, 1987) [28], and the evolutionary analyses were conducted in MEGA7 according to Kumar et al. 2016 [29]. Based on the mentioned characteristics, it was confirmed that the strain LGO5 belongs to Nocardiopsis sp., and it has been recorded in the GenBank database (accession No. MF619951). Additionally, the genomic DNA of LGO5 has been tested twice in PCR analysis using either a bacteria-specific primer or a fungi-specific primer. The results showed a specific band in the PCR product using the bacteria-specific primer (Figure 5b). Contrarily, the PCR product using the fungal primer did not show any band on agarose gel electrophoresis (Figure 5f).
Figure 4.
Evolutionary relationships of taxa related to Nocardiopsis sp. LGO5 based on 16S rRNA gene sequence using the Neighbour-Joining method. The analysis involved 24 nucleotide sequences.
Figure 5.
Agarose gel electrophoresis of LGO5 genomic DNA: (Lane a) DNA ladder 100 bp; (Lane b) PCR product of LGO5 genomic DNA using bacteria-specific primer; (Lane c) Positive control sample for known bacterial genomic DNA; (Lane d) Negative control sample using water instead of genomic DNA; (Lane e) Positive control sample for known fungal genomic DNA; (Lane f) PCR product of LGO5 genomic DNA using fungi-specific primer.
2.3. Structure Elucidation
Chemical screening, monitored by thin-layer chromatography (TLC), of the bacterial extract exhibited several bands with a wide range of polarities. Non-UV-absorbing compounds were detected as intensive pink to violet bands with anisaldehyde/sulfuric acid. UV absorbing bands exhibited pink, yellow, or brown coloration with anisaldehyde/sulfuric acid. Separation of the produced metabolites by the strain was carried out using a series of chromatographic techniques. The physicochemical properties of terretonin N (1) are listed in Table 1.
Table 1.
Physico-chemical properties of terretonin N (1).
Compound 1, a moderately polar colourless solid, appeared on TLC as an intensive pink spot that changed to violet on spraying with anisaldehyde/sulfuric acid and heating. As it did not show UV absorption or fluorescence, characteristic for conjugated systems, we supposed it to be a terpenoid [30]. The molecular formula of 1 was determined as C26H38O7 by negative mode ESI-HR-MS (Table 1), indicating the presence of eight double bond equivalents (DBE).
The 1H-NMR spectrum together with HSQC data (Table 2) exhibited six methyl singlets at δH 2.03 (s, H3-23), 1.96 (s, H3-27), 1.68 (s, H3-20), 1.62 (s, H3-24), 1.28 (s, H3-22), 0.86 (s, H3-21), and one methyl doublet at δH 1.38 (d, 6.4 Hz, H-25). An oxymethine group resonating at δH 4.81 (m, H-17) was shown to be attached to a methyl group (H-25) based on the coupling constant (6.4 Hz) and H,H COSY crosspeaks. A pair of two singlets at δH 5.06 (s, H-19a) and 5.16 (s, H-19b) suggested a vinylidene moiety. Signals of further three oxymethine groups were detected; two of them are multiplet at δH 4.81 (H-11) and triplet (3.0 Hz) at δH 4.55 (H-3), while the third one resonated as triplet at δH 4.35 (H-6). A singlet of a non-oxygenated methine group δH 2.58 (s, H-14), as well as two doublets of doublets at δH 2.74 (dd, 14.5, 2.7 Hz, H-7a) and 1.19 (m, H-7b) corresponding to a methylene group, were detected. Further multiplet signals were detected at δH 2.08–0.95 with an integral of 6H, corresponding to two additional methylene groups (H2-1, H2-2) and two methine groups (H-5, H-9).
Table 2.
13C (125 MHz) and 1H (500 MHz) NMR data of terretonin N (1) in CDCl3.
The 13C/DEPT/HSQC NMR spectra showed 26 resonance signals, corresponding to seven methyl groups (δC 24.2–14.6 [C-20–25,27]), three methylene groups (δC 50.3–22.5 [C-1,2,7]), and seven methine groups, among them four sp3 oxymethine groups (δC 79.4–76.0 [C-3,6,11,17]) and three non-oxygenated ones (δC 61.3–51.5 [C-5,9,14]). Nine quaternary carbons were found, among them one ketone carbonyl (206.8, C-18), two ester carbonyls of an α-lactone (δC 169.4, C-15) and an acetate residue (δC 170.6, C-26), and two sp2 carbons for an exocyclic double bond (δC 147.9 [C-12], 114.5 [C-19]). Further four quaternary carbons resonate in the aliphatic region (δC 50.0–37.1 [C-4,8,10,13]). The evidence mentioned above and the eight double bond equivalents deduced from the molecular formula suggested that compound 1 is a tetracyclic compound.
According to H,H-COSY and HMBC experiments (Figure 6), compound 1 shows the following structural features: In ring A, the acetate residue is connected to the hydroxyl group at position 3 due to a visible 3J HMBC correlation between H-3 and C-26 (170.6). The gem-methyls (C-21,22) are attached to C-4. In ring B, the clear HMBC correlations from H-6 (4.35) to C-10 (38.1) and C-8 (37.1), and the H,H-COSY crosspeaks between H-6 and both neighboring protons (H-5 [1.25] and H-7 [2.74, 1.19]), completed the assignment. The HMBC correlations between H3-20 (1.68) and carbons C-1, 5, 9, and 10 established the fusion between rings A and B via C-5 and C-10. Alternatively, the direct fusion between rings B and C was proven through carbons C-8 and C-9 as the existence of an HMBC correlation from H3-23 (2.03) versus carbons C-7,8,9, and 14. The assignment of the vinylidene moiety at C-12 is based on the 3J HMBC correlations of corresponding methylene protons (H-19a/19b [5.06, 5.16]) with C-11 and C-13. The connectivity between rings C and D through C-13 and C-14 was verified by the HMBC correlation directed from the methyl H3-24 (1.62) towards C-12, 13, 14 and 18. The keto-lactone of ring D was identified by the 3J HMBC crosspeak between H-17 (4.81) and the lactone carbonyl C-15 (169.4), while the doublet methyl H3-25 (1.38) exhibited a 3J correlation towards the ketone carbonyl C-18 (206.8). According to the chromatographic behavior and based on the spectroscopic and mass spectrometric analyses together with data base searches, structure 1 was confirmed as a new meroterpenoidal/sesterterpenoidal compound and was given the trivial name terretonin N.
Figure 6.
COSY (
) and key HMBC (
) correlations of terretonin N (1).
) and key HMBC (
) correlations of terretonin N (1).
The relative stereochemistry of compound 1 was deduced from NOESY cross-peaks: H-3, CH3-21, CH3-20, CH3-23, CH3-24, and CH3-25 are located on one side of the molecule, while H-5, H-9, H-14, H-11, H-17, and CH3-22 point to the opposite side (Figure 7). Furthermore, the coupling constant of H-3 (J ~ 3.0 Hz) is indicative for its equatorial configuration, and, hence, the acetoxy residue has an axial orientation. The absolute configuration of terretonin N was established by X-ray structure determination (anomalous dispersion) of a single crystal grown from an acetone solution. The chiral carbons C-3, C-5, C-6, C-8, C-9, C-10, C-11, C-13, and C-17 have (S) configuration, while C-14 is the only stereocenter that has an (R) configuration (Figure 8).
Figure 7.
Key NOESY (
) correlations of terretonin N (1).
) correlations of terretonin N (1).
Figure 8.
X-ray single crystal of terretonin N (1).
Since the discovery of terpenes (more than 150 years ago), researchers have reported approximately 50,000 different terpenes derived from plants and fungi. Bacteria and other microorganisms are known to produce terpenes as well. However, they have received much less attention [31,32]. Cane et al. (Brown University, Providence, RI, USA) have proven the genetic capacity of bacteria to create terpenes with structural diversity [33,34,35,36]. During their studies 15 years ago, they have concluded, through the genome data gathered from many Streptomyces spp., that the latter have gene sequences that are similar to those encoding terpene synthases in plants and fungi. Consequently, they proved that actinobacteria indeed have genes for terpene synthases and that those enzymes could be used to make terpenes [37,38].
Terretonins are meroterpenoids biosynthetically derived from 3,5-dimethylorsellinic acid (DMOA), which is cyclized by terpene cyclase to form a terpenoid [39]. Recently, it has been reported that bacteria harbor numerous genes coding for terpene cyclases [40], in addition to terpene synthases, which are widely distributed in bacteria as well [11]. This underscores the eminent capability of bacteria to produce terpenoids with high similarity to those obtained from fungi. For example, merochlorin A, a sesterterpenoid, has been isolated from Streptomyces sp. [41]. Further intensive search in the literature and in the National Center for Biotechnology Information (NCBI) database (https://www.ncbi.nlm.nih.gov/protein/) revealed that thousands of gene cluster homologs encoding enzymes proposed to be involved in terretonin biosynthesis [42] have been identified in actinobacteria. These enzymes include terpene synthase and terpene cyclase, aromatic prenyltransferase, monooxygenase, polyketide synthases, methyltransferase, phytanoyl-CoA dioxygenase, epoxidase, cytochrome P450 monooxygenases, and short chain dehydrogenases. Such kinds of enzymes commonly exist in the bacterial systems as well. Additional studies and approaches are required to support the production of terretonins from bacteria, including the study of the full bacterial genome to characterize the gene cluster for terretonin biosynthesis.
2.4. Biological Activity
The crude extract of Nocardiopsis sp. LGO5 was tested against a set of microorganisms using the agar diffusion technique (Table 3), showing potent activity against P. aeruginosa and S. cerevisiae; (13 and 14 mm, respectively). It exhibited low to moderate activity against E. coli DSMZ 1058, B. subtilis DSMZ 704, P. agarici DSMZ 11810, M. luteus DSMZ 1605, S. warneri DSMZ 20036, S. aureus, and C. albicans. The pure compound 1 displayed pronounced activity in the antibacterial assay against the Gram positive S. warneri (zone of inhibition 15 mm), which even exceeds that of the positive control gentamycin (14 mm) (Table 4). However, it showed only low activity (7–8 mm) against the Gram negative P. agaraci and E. coli.
Table 3.
Antimicrobial activities of LGO5 crude extract using agar diffusion test (mm diameter).
Table 4.
Antimicrobial activities of pure compounds using agar diffusion test (mm diameter).
The bacterial extract and the purified compound terretonin N (1) did not exhibit any significant in vitro cytotoxicity against the human cervix carcinoma cell line KB-3-1.
3. Materials and Methods
3.1. General Experimental Details
Column chromatography was carried out on silica gel (0.06–0.2 mm, Merck, Darmstadt, Germany) deactivated with 3% aq. oxalic acid. Gel filtration was carried out on Sephadex LH-20 (GE Healthcare, Uppsala, Sweden). Preparative TLC (0.5 mm thick) and analytical TLC was performed on Merck pre-coated silica gel 60 PF254+366 plates (Merck, Darmstadt, Germany). Rf values of the bioactive compounds and visualization of their chromatograms was carried out under UV light (254 and 366 nm) and further by spraying with anisaldehyde/sulfuric acid followed by heating. High Resolution ESI-MS was done on a Micromass AC-TOF micro mass spectrometer (Micromass, Agilent Technologies 1200 series, Waldbronn, Germany). Optical rotations were measured on a P-1020 polarimeter (JASCO, Tokyo, Japan). 1D NMR and 2D (COSY, HMQC, HMBC, NOESY) NMR spectra were recorded on an Avance 500 MHz spectrometer (Bruker, Rheinstetten, Germany) at 500 MHz (1H) and 125 MHz (13C) at 298 K using the residual solvent peaks as a reference. X-ray crystallographic data of compound 1 was collected on a Rigaku Supernova diffractometer (Rigaku Innovative Technologies, Auburn Hills, MI, USA).
3.2. Isolation of Nocardiopsis sp. LGO5
The marine strain LGO5 was isolated from a sediment sample collected from a lake in Helwan, Egypt. It was cultivated on starch nitrate agar (20.0 g L−1 starch, 2.0 g L−1 KNO3, 1.0 g L−1 K2HPO4, 0.5 g L−1 MgSO4·7H2O, 0.5 g L−1 NaCl, 0.01 g L−1 FeSO4·7H2O, 3.0 g L−1 CaCO3, 20.0 g L−1 agar and 1000 mL of 50% sea water). The pH was adjusted to pH 7.2. The sediment sample was suspended into sterilized sea water and incubated for 30 min into a reciprocal water bath at 30 °C. The suspension was applied for a series of tenfold dilution with sterile sea water and platted (100 µL) on prepared media. The plates were then incubated at 30 °C for 6–8 weeks. Colonies with distinct morphological characteristics were selected and transferred onto freshly prepared solid media and stored in refrigerator at 4 °C. The strain LGO5 is deposited in the Microbial Chemistry Department, National Research Centre (NRC), Egypt.
3.3. DNA Isolation and 16S rRNA Gene Sequencing
The strain was inoculated in a 100 mL Erlenmeyer flask containing 50 mL of ISP2 medium (10 g L−1 malt extract, 4 g μL−1 yeast extract and 4 g L−1 glucose (pH 7.2) and incubated at 28 °C for 3 days. Genomic DNA of the strain was isolated using bacterial genome DNA isolation kit (Qiagen-kit: DNeasy Blood & Tissue Cat. No.: 69504) following the manufacturer’s manual.
The 16S rRNA gene was amplified from bacterial genomic DNA using primer set 9F (5′-GAGTTTGATCCTGGCTCAG3′)/1541R (5′-AAGGAGGTGATCCAACC3′). The following amplification profile was used: an initial denaturation step at 94 °C for 2 min was followed by 30 amplification cycles of 94 °C for 1 min, 55 °C for 1 min, 72 °C for 2 min, and a final extension step of 72 °C for 2 min. After agarose gel electrophoresis, the PCR product was detected and visualized by (UV) fluorescence after ethidium bromide staining [43]. PCR-clean-up was performed according to the description manual in Qiagen-kit: 28104. The 16S rRNA gene sequence was aligned using BLAST (blastn) available at NCBI database (National Centre Biotechnology Information, http://www.ncbi.nlm.nih.gov). The phylogenetic tree was constructed using neighbour-joining tree method using the software MEGA7. Further analyses for genomic DNA of LGO5 have been carried out using bead beating-extracted DNA and spin column purification by ABT DNA mini extraction kit (Applied Biotechnology Co. Ltd., Ismailia, Egypt). Briefly, the bacterial spores were suspended in 200 uL of distilled water containing zirconia silica beads, then homogenized by vortex mixing. Subsequently, the mixture was incubated at 100 °C for 15 min. Furthermore, the lysis buffer and proteinase K were added to the sample under investigation, and DNA extraction was preceded according to manufacturer instructions. The 16S rRNA gene was amplified using primer set (5′-AGAGTTTGATC(C/A)TGGCTCAG-3′)/(5′TACGG(C/T)TACCTTGTTACGACTT-3′). Additionally, the genomic DNA was further investigated using fungi-specific primer set ITS1 (5′-TCCGTAGGTGAACCTGCGG-3′)/ITS4 (5′-TCCTCCGCTTATTGATATGC-3′) to amplify 5.8S rRNA gene and ITS (Internal Transcript Spacer) regions (if exist). The following amplification profile was used: an initial denaturation step at 95 °C for 5 min was followed by 35 amplification cycles of 55 °C for 30 s, 72 °C for 90 s, and a final extension step at 72 °C for 3 min. The PCR products were detected and visualized by (UV) fluorescence after ethidium bromide staining.
3.4. Phenotypic Characterization of the Strain
The cultivation characteristics of the strain isolate LGO5 were studied according to the guidelines established in the International Streptomyces Project [17]. The aerial mycelium, pigmentation, and morphological features were examined after its growth on different ISP media. Physiological and biochemical characteristics were studied by NaCl tolerance [44], and different carbon sources utilization [17]. For microscopic examination, the bacterial strain has been cultivated on starch nitrate agar plates using two individual conditions: (a) in the presence of nystatin [100,000 IU/mL] (50 μL/500 mL media) as antifungal agent; and (b) in absence of the antifungal agent. The bacterial cells obtained during both were examined for spore chain morphology under light microscope (Olympus CH-2) using 40× lens (Figure 3). Electron micrograph has been taken using Transmission Electron Microscope (TEM) at National Research Centre (NRC), Egypt (Figure 4a)
3.5. Large-Scale Fermentation and Isolation
The spore suspension of strain LGO5 was inoculated into 100 mL of ISP2 medium and cultivated at 30 °C for 3 days as seed culture. 5 mL of seed culture were aseptically transferred to inoculate 1 L Erlenmeyer flasks (12 flasks) containing modified rice medium composition: 100 g commercial rice and 100 mL 50% sea water containing 0.4% yeast extract and 1% malt extract. The flasks were incubated for 14 days at 35 °C. After harvesting, the obtained broth was macerated in methanol (2.5 L). The methanol extract was separated by filtration, and concentrated in vacuo, and the remaining water residue was re-extracted with ethyl acetate. The obtained ethyl acetate extract was finally concentrated in vacuo to dryness and then further purified.
The crude extract (3.9 g) was separated by column chromatography on silica gel (60 × 3 cm) with a cyclohexane/dichloromethane (DCM)/methanol (MeOH) gradient, 0.5 L cyclohexane, 0.5 L cyclohexane/DCM [8:2], 0.5 L cyclohexane/DCM [6:4], 0.5 L cyclohexane/DCM [4:6], 0.5 L cyclohexane/DCM [2:8], 0.5 L DCM, 0.3 L DCM/MeOH [97:3], 0.3 L DCM/MeOH [95:5], 0.3 L DCM/MeOH [90:10], 0.3L DCM/MeOH [80:20], and 0.3 L MeOH. According to TLC monitoring, three fractions were obtained: FI (0.97 g), FII (1.2 g), and FIII (0.3 g). Fraction FI was highly nonpolar, mostly fats, and was discarded. Purification of FII on Sephadex LH-20 (CH2Cl2/40% MeOH) yielded anthranilic acid (1 mg) and indole-3-acetic acid (1.2 mg) in addition to four sub-fractions, FIIa, FIIb, FIIc, and FIId. Sub-fraction FIIa was purified using Sephadex LH-20 (CH2Cl2/40% MeOH) to afford terretonin N (1, 8 mg) as colorless needles. The diastereomers (3R,4R)-3,4-dihydroxy-3-methylpentan-2-one and (3S,4R)-3,4-dihydroxy-3-methylpentan-2-one (6 mg) were obtained as colourless oil from sub-fraction FIIb after its application to silica gel (column 60 × 1.5 cm) and elution with CH2Cl2/MeOH gradient. Further purification of sub-fraction FIIc on Sephadex LH-20 (CH2Cl2/40% MeOH) gave (2 mg) of tryptamine. The last sub-fraction FIId was purified on Sephadex LH-20 (CH2Cl2/40% MeOH) to afford terrein (4 mg). Finally, application of fraction FIII to Sephadex LH-20 (CH2Cl2/40% MeOH) afforded sitosteryl-3β-d-glucoside (3 mg) as colorless solid.
3.6. Antimicrobial Activity Assay
Antimicrobial activity testing of the bacterial crude extract and compound 1 was carried out against a set of microorganisms using paper-disk diffusion assay [45] with some modifications according to our previous work [7].
3.7. Cytotoxicity Assays
Methodology of the cytotoxic assaying of the bacterial extract and compound 1 against the human cervix carcinoma cells KB-3-1 was carried out according to our previous work [7].
3.8. Crystal Data
Terretonin N: C29H44O8 (Terretonin N, [C26H38O7] + acetone [C3H6O], N = 520.64 g/mol), monoclinic, space group P21 (no. 4), a = 6.95341(3) Å, b = 20.21914(9) Å, c = 9.76794(5) Å, β = 97.2649(5)°, V = 1362.269(11) Å3, Z = 2, T = 100.0(1) K, μ(CuKα) = 0.744 mm−1, Dcalc = 1.269 g/cm3, 76,570 reflections measured (8.746° ≤ 2Θ ≤ 152.702°), 5690 unique (Rint = 0.0248, Rsigma = 0.0079), which were used in all calculations. The final R1 was 0.0221 for 5677 reflections with I > 2σ(I) and wR2 was 0.0597 for all data, Flack parameter −0.01(2). For further details see the CIF file attached in the Supplementary Materials. CCDC 1575850 contains the supplementary crystallographic data for this paper. These data can be obtained free of charge via http://www.ccdc.cam.ac.uk/conts/retrieving.html.
4. Conclusions
A new, highly oxygenated, and unique tetracyclic 6-hydroxymeroterpenoid, terretonin N (1) was isolated from the marine-derived Nocardiopsis sp. LGO5 together with further seven known metabolites. The chemical structure of 1 was elucidated by extensive studies of 1D NMR, 2D NMR, and ESI HR MS data. The configuration of 1 was established by NOESY and X-ray crystallography. Terretonin N (1) exhibited high activity against Gram-positive bacteria with no cytotoxicity, reflecting its importance in pharmacology and pharmacognosy studies concerning drug discovery and its development.
Supplementary Materials
The supplementary data are available online.
Acknowledgments
The authors are thankful to the NMR and MS Departments in Bielefeld University for the spectral measurements. We thank Carmela Michalek for biological activity testing and Marco Wißbrock for technical assistance. This research work has been financed by the German Academic Exchange Service (DAAD) with funds from the German Federal Foreign Office in the frame of the Research Training Network “Novel Cytotoxic Drugs from Extremophilic Actinomycetes” (Project ID 57166072). We thank the Open Access Publication Fund of Bielefeld University for the article processing charge.
Author Contributions
A.H., M.S., A.S.A. and N.S. conceived and designed the experiments; A.H. performed the extraction and isolation; A.H. and M.S. carried out the spectroscopic characterization of the compounds; A.S.A. performed the isolation, taxonomy, and fermentation of the producing strain; H.G.S. performed and analyzed the X-ray data; M.F. analyzed the biological data; A.F.E.-H. and T.M.A.I. participated in the manuscript revision; all authors participated in manuscript preparation.
Conflicts of Interest
The authors declare no conflict of interest.
References
- Laatsch, H.; AntiBase, A. Data Base for Rapid Structural Determination of Microbial Natural Products, and Annual Updates; Wiley-VCH: Weinheim, Germany. Available online: http://wwwuser.gwdg.de/~ucoc/laatsch/AntiBase.htm (accessed on 28 January 2016).
- Butler, M.S. The role of natural product chemistry in drug discovery. J. Nat. Prod. 2004, 67, 2141–2153. [Google Scholar] [CrossRef] [PubMed]
- Eliwa, E.M.; Abdel-Razek, A.S.; Frese, M.; Halawa, A.H.; El-Agrody, A.M.; Bedair, A.H.; Sewald, N.; Shaaban, M. New bioactive compounds from the marine-derived actinomycete Nocardiopsis lucentensis sp. ASMR2. Zeitschrift für Naturforschung B 2017, 72, 351–360. [Google Scholar] [CrossRef]
- Singh, S.B.; Zink, D.L.; Guan, Z.; Collado, J.; Pelaez, F.; Felock, P.J.; Hazuda, D.J. Isolation, structure and HIV-1 integrase inhibitory activity of xanthoviridicatin E and F, two novel fungal metabolites produced by penicillium chrysogenum. Helv. Chim. Acta 2003, 86, 3380–3385. [Google Scholar] [CrossRef]
- Zhang, H.W.; Song, Y.C.; Tan, R.X. Biology and chemistry of endophytes. Nat. Prod. Rep. 2006, 23, 753–771. [Google Scholar] [CrossRef] [PubMed]
- Song, Y.C.; Li, H.; Ye, Y.H.; Shan, C.Y.; Yang, Y.M.; Tan, R.X. Endophytic naphthopyrone metabolites are co-inhibitors of xanthine oxidase, SW1116 cell and some microbial growths. FEMS Microbiol. Lett. 2004, 241, 67–72. [Google Scholar] [CrossRef] [PubMed]
- Hamed, A.; Abdel-Razek, A.S.; Frese, M.; Wibberg, D.; El-Haddad, A.F.; Ibrahim, T.M.A.; Kalinowski, J.; Sewald, N.; Shaaban, M. New Oxaphenalene Derivative from marine-derived Streptomyces griseorubens sp. ASMR4. Zeitschrift für Naturforschung B 2017, 72, 53–62. [Google Scholar] [CrossRef]
- Debnath, M.; Paul, A.K.; Bisen, P.S. Natural Bioactive Compounds and Biotechnological potential of Marine Bacteria. Curr. Pharm. Biotechnol. 2007, 8, 253–260. [Google Scholar] [CrossRef] [PubMed]
- Blunt, J.W.; Copp, B.R.; Hu, W.P.; Munro, M.H.G.; Northcote, P.T.; Prinsep, M.R. Marine Natural Products. Nat. Prod. Rep. 2007, 24, 31–86. [Google Scholar] [CrossRef] [PubMed]
- Liu, X.-H.; Miao, F.-P.; Qiao, M.-F.; Cichewicz, R.H.; Ji, N.-Y. Terretonin, ophiobolin, and drimane terpenes with absolute configurations from an algicolous Aspergillus ustus. RSC Adv. 2013, 3, 588–595. [Google Scholar] [CrossRef]
- Yamada, Y.; Kuzuyama, T.; Komatsu, M.; Shin-ya, K.; Omura, S.; Cane, D.E.; Ikeda, H. Terpene synthases are widely distributed in bacteria. Proc. Natl. Acad. Sci. USA 2015, 112, 857–862. [Google Scholar] [CrossRef] [PubMed]
- Shirai, M.; Okuda, M.; Motohashi, K.; Imoto, M.; Furihata, K.; Matsuo, Y.; Katsuta, A.; Shizuri, Y.; Seto, H. Terpenoids produced by actinomycetes: Isolation, structural elucidation and biosynthesis of new diterpenes, gifhornenolones A and B from Verrucosispora gifhornensis YM28-088. J. Antibiot. 2010, 63, 245–250. [Google Scholar] [CrossRef] [PubMed]
- Schneider, K.; Graf, E.; Irran, E.; Nicholson, G.; Stainsby, F.M.; Goodfellow, M.; Borden, S.A.; Keller, S.; Süssmuth, R.D.; Fiedler, H.-P. Bendigoles A–C, New Steroids from Gordonia australis Acta 2299. J. Antibiot. 2008, 61, 356–364. [Google Scholar] [CrossRef] [PubMed]
- Springer, J.P.; Dorner, J.W.; Cole, R.J.; Cox, R.H. Terretonin, a toxic compound from aspergillus terreus. J. Org. Chem. 1979, 44, 4852–4854. [Google Scholar] [CrossRef]
- Li, G.-Y.; Li, B.-G.; Yang, T.; Yin, J.-H.; Qi, H.-Y.; Liu, G.-Y.; Zhang, G.-L. Sesterterpenoids, Terretonins A–D, and an Alkaloid, Asterrelenin, from Aspergillus terreus. J. Nat. Prod. 2005, 68, 1243–1246. [Google Scholar] [CrossRef] [PubMed]
- Liu, H.B.; Drada-Ebel, R.; Ebel, E.R.; Schulz, W.B.; Draeger, S.; Mueller, W.E.G.; Wary, V.; Lin, W.H.; Proksch, P. Ophiobolin sesterterpenoids and pyrrolidine alkaloids from the sponge-derived fungus Aspergillus ustus. Helv. Chim. Acta 2011, 94, 623–631. [Google Scholar] [CrossRef]
- Liu, H.B.; Edrada-Ebel, R.; Ebel, R.; Schulz, W.B.; Draeger, S.; Mueller, W.E.G.; Wary, V.; Lin, W.H.; Proksch, P. Drimane Sesquiterpenoids from the Fungus Aspergillus ustus Isolated from the Marine Sponge Suberites domuncula. J. Nat. Prod. 2009, 72, 1585–1588. [Google Scholar] [CrossRef] [PubMed]
- Kikuchi, H.; Tsukitani, Y.; Kobayshi, M.; Kitagawa, I. Marine Natural Products. XI. An Antiinflammatory Scalarane-type Bishomosesterterpene, Foliaspongin, from the Okinawan Marine Sponge Phyllospongia foliascens (PALLAS). Chem. Pharm. Bull. 1983, 31, 552–556. [Google Scholar] [CrossRef]
- Charan, R.D.; Mckee, T.C.; Boyd, M.R. Thorectandrols C, D, and E, New Sesterterpenes from the Marine Sponge Thorectandra sp. J. Nat. Prod. 2002, 65, 492–495. [Google Scholar] [CrossRef] [PubMed]
- Terem, B.; Scheuer, P.J. Scalaradical derivatives from the nurdibranch chromodoris youngbleuthi and the sponge Spongia Oceania. Tetrahedron 1986, 42, 4409–4412. [Google Scholar] [CrossRef]
- Kazlauskas, R.; Murphy, P.T.; Wells, R.J. Five new C26 tetracyclic terpenes from a sponge (Lendenfeldia sp.). Aust. J. Chem. 1982, 35, 51–59. [Google Scholar] [CrossRef]
- Bowden, B.F.; Coll, J.C.; Li, H.; Cambie, R.C.; Kernan, M.R.; Bergquist, P.R. New Cytotoxic Scalarane Sesterterpenes from the Dictyoceratid Sponge Strepsichordaia lendenfeldi. J. Nat. Prod. 1992, 55, 1234–1240. [Google Scholar] [CrossRef] [PubMed]
- Komai, S.-I.; Hosoe, T.; Itabashi, T.; Nozawa, K.; Okada, K.; de Campos Takaki, G.M.; Yaguchi, T.; Takizawa, K.; Fukushima, K.; Kawai, K.-I. Two New Meroterpenoids, Penisimplicin A and B, Isolated from Penicillium simplicissimum. Chem. Pharm. Bull. 2005, 53, 1114–1117. [Google Scholar] [CrossRef] [PubMed]
- Shaaban, M. Bioactive Secondary Metabolites from Marine and Terrestrial Bacteria: Isoquinolinequinones, Bacterial Compounds with a Novel Pharmacophor. Ph.D. Thesis, Georg-August University, Göttingen, Germany, 2004. [Google Scholar]
- Agzamova, M.A.; Isaev, I.M.; Rakhmatov, K.A. Steroids and Glycosides from Astragalus turczaninowii. Chem. Nat. Compd. 2017, 53, 398–399. [Google Scholar] [CrossRef]
- Ma, Q.; Ding, W.; Chen, Z.; Ma, Z. Bisamides and rhamnosides from mangrove actinomycete Streptomyces sp. SZ-A15. Nat. Prod. Res. 2017. [Google Scholar] [CrossRef] [PubMed]
- Nagia, M.M.S.; El-Metwally, M.M.; Shaaban, M.; El-Zalabani, S.M.; Hanna, A.G. Four butyrolactones and diverse bioactive secondary metabolites from terrestrial Aspergillus flavipes MM2: Isolation and structure determination. Org. Med. Chem. Lett. 2012, 2, 9. [Google Scholar] [CrossRef] [PubMed]
- Saitou, N.; Nei, M. The neighbor-joining method: A new method for reconstructing phylogenetic trees. Mol. Biol. Evol. 1987, 4, 406–425. [Google Scholar] [PubMed]
- Kumar, S.; Stecher, G.; Tamura, K. MEGA7: Molecular Evolutionary Genetics Analysis version 7.0 for bigger datasets. Mol. Biol. Evol. 2016, 33, 1870–1874. [Google Scholar] [CrossRef] [PubMed]
- Shaaban, M.; Shaaban, K.A.; Abd-Alla, H.I.; Hanna, A.G.; Laatsch, H. Dendrophen, a Novel Glycyrrhetyl Amino Acid from Dendronephthya hemprichi. Zeitschrift für Naturforschung B 2011, 66, 425–432. [Google Scholar] [CrossRef]
- Aroma of Basil, Scent of Pine. Bacteria Could Be Rich Source for Making Terpenes. 22 December 2014 Media Contact: Kevin Stacey 401-863-3766. Available online: https://news.brown.edu/articles/2014/12/terpenes (accessed on 25 January 2018).
- Yamada, Y.; Arima, S.; Nagamitsu, T.; Johmoto, K.; Uekusa, H.; Eguchi, T.; Shin-ya, K.; Cane, D.E.; Ikeda, H. Novel terpenes generated by heterologous expression of bacterial terpene synthase genes in an engineered Streptomyces host. J. Antibiot. 2015, 68, 385–394. [Google Scholar] [CrossRef] [PubMed]
- Cane, D.E.; Ikeda, H. Exploration and mining of the bacterial terpenome. Acc. Chem. Res. 2012, 45, 463–472. [Google Scholar] [CrossRef] [PubMed]
- Zhu, D.; Seo, M.J.; Ikeda, H.; Cane, D.E. Genome mining in streptomyces. Discovery of an unprecedented P450-catalyzed oxidative rearrangement that is the final step in the biosynthesis of pentalenolactone. J. Am. Chem. Soc. 2011, 133, 2128–2131. [Google Scholar] [CrossRef] [PubMed]
- Doud, E.H.; Perlstein, D.L.; Wolpert, M.; Cane, D.E.; Walker, S. Two distinct mechanisms for TIM barrel prenyltransferases in bacteria. J. Am. Chem. Soc. 2011, 133, 1270–1273. [Google Scholar] [CrossRef] [PubMed]
- Takamatsu, S.; Lin, X.; Nara, A.; Komatsu, M.; Cane, D.E.; Ikeda, H. Characterization of a silent sesquiterpenoid biosynthetic pathway in Streptomyces avermitilis controlling epi-isozizaene albaflavenone biosynthesis and isolation of a new oxidized epi-isozizaene metabolite. Microb. Biotechnol. 2011, 4, 184–191. [Google Scholar] [CrossRef] [PubMed]
- Hu, Y.; Chou, W.K.; Hopson, R.; Cane, D.E. Genome mining in Streptomyces clavuligerus: Expression and biochemical characterization of two new cryptic sesquiterpene synthases. Chem. Biol. 2011, 18, 32–37. [Google Scholar] [CrossRef] [PubMed]
- Aaron, J.A.; Lin, X.; Cane, D.E.; Christianson, D.W. Structure of epi-isozizaene synthase from Streptomyces coelicolor A3(2), a platform for new terpenoid cyclization templates. Biochemistry 2010, 49, 1787–1797. [Google Scholar] [CrossRef] [PubMed]
- Matsuda, Y.; Awakawa, T.; Itoh, T.; Wakimoto, T.; Kushiro, T.; Fujii, I.; Ebizuka, Y.; Abe, I. Terretonin Biosynthesis Requires Methylation as Essential Step for Cyclization. ChemBioChem 2012, 13, 1738–1741. [Google Scholar] [CrossRef] [PubMed]
- Dickschat, J.S. Bacterial terpene cyclases. Nat. Prod. Rep. 2016, 33, 87–110. [Google Scholar] [CrossRef] [PubMed]
- Sakoulas, G.; Nam, S.-J.; Loesgen, S.; Fenuical, W.; Gensen, P.R.; Nizet, V.; Hensler, M. Novel bacterial metabolite merhochlorin A demonstrates in vitro activities against multi-drug resistant methicillin-resistant Staphylococcus aureus. PLoS ONE 2012, 7, e29439. [Google Scholar] [CrossRef] [PubMed]
- Guo, C.-J.; Knox, B.P.; Chiang, Y.-M.; Lo, H.-C.; Sanchez, J.-F.; Lee, K.-H.; Oakley, B.-R.; Bruno, K.S.; Wang, C.C.C. Molecular Genetic Characterization of a Cluster in A. terreus for Biosynthesis of the Meroterpenoid Terretonin. Org. Lett. 2012, 14, 5684–5687. [Google Scholar] [CrossRef] [PubMed]
- Kumar, V.; Bharti, A.; Gusain, O.; Bisht, G.S. An improved method for isolation of genomic DNA from filamentous actinomycetes. J. Eng. Technol. Manag. 2010, 2, 10–13. [Google Scholar]
- Tresner, H.D.; Hayes, J.A.; Backus, E.J. Differential tolerance of streptomycetes to sodium chloride as a taxonomic aid. Appl. Microbiol. 1968, 16, 1134–1136. [Google Scholar] [PubMed]
- Bauer, A.W.; Kirby, W.M.; Sherris, J.C.; Truck, M. Antibiotic susceptibility testing by a standardized single disk method. Am. J. Clin. Pathol. 1966, 45, 493–496. [Google Scholar] [PubMed]
Sample Availability: Sample of compound 1 is available from the authors. |
© 2018 by the authors. Licensee MDPI, Basel, Switzerland. This article is an open access article distributed under the terms and conditions of the Creative Commons Attribution (CC BY) license (http://creativecommons.org/licenses/by/4.0/).